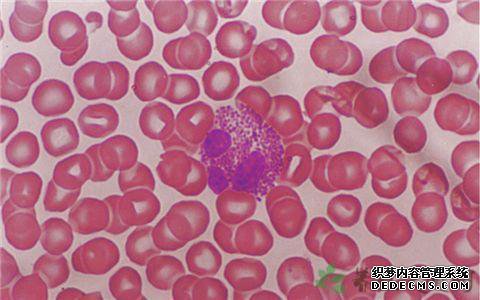

热门文章
随机文章
嗜酸性粒细胞EO正常吗?
嗜酸性粒细胞EO正常吗?
高嗜酸性粒细胞
你好:我EO嗜酸性粒细胞和嗜酸性粒细胞BA为0,是什么呢?
嗜酸性粒细胞比率(EO%)↓结果:0
003
嗜酸性粒细胞百分比(EO%)显示在医疗报告表中。
正常值的8%为0。
嗜酸性粒细胞的绝对值(EO#)
嗜酸性粒细胞(EO)的比率为0。
058↑
您好
我的身体检查显示嗜酸性粒细胞比率(EO)为6。
71,正常范围。
EO#嗜酸性粒细胞值为0。
04
我的嗜酸性粒细胞为EO#,结果为0。
检验报告970的标准值是多少?
嗜酸性粒细胞百分比(EO%)高于正常水平

你好:我EO嗜酸性粒细胞和嗜酸性粒细胞BA为0,是什么呢?
嗜酸性粒细胞比率(EO%)↓结果:0
003
嗜酸性粒细胞百分比(EO%)显示在医疗报告表中。
正常值的8%为0。
嗜酸性粒细胞的绝对值(EO#)
嗜酸性粒细胞(EO)的比率为0。
058↑
您好
我的身体检查显示嗜酸性粒细胞比率(EO)为6。
71,正常范围。
EO#嗜酸性粒细胞值为0。
04
我的嗜酸性粒细胞为EO#,结果为0。
检验报告970的标准值是多少?
嗜酸性粒细胞百分比(EO%)高于正常水平